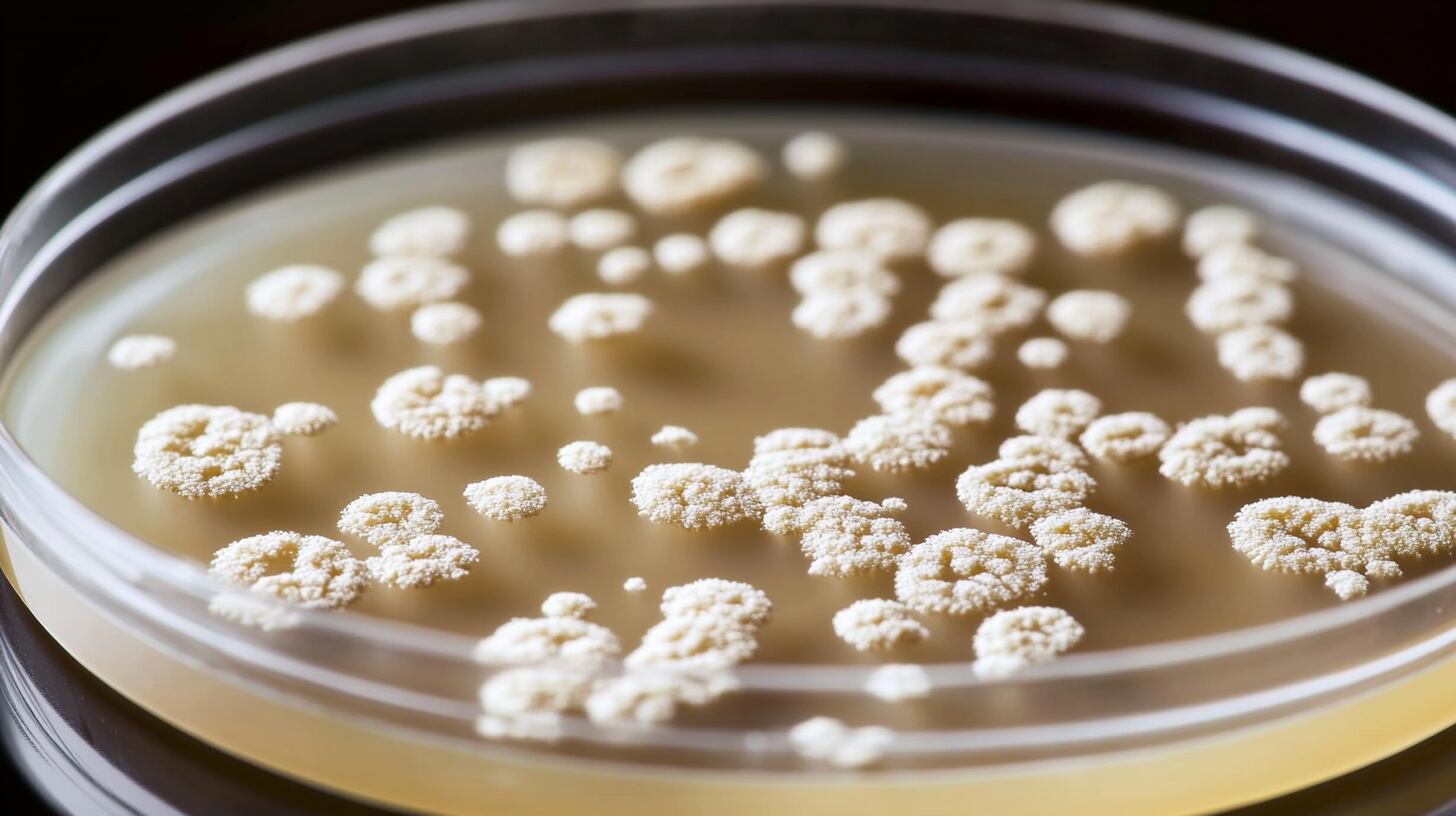
El impacto de la RAM se extiende a la economía y la subsistencia, ya que 1300 millones de personas dependen del ganado y más de 20 millones de la acuicultura, y el sufrimiento animal genera pérdidas y compromete la seguridad alimentaria (Imagen Ilustrativa Infobae)

La resistencia a los antimicrobianos (RAM) preocupa a los expertos y a organismos internacionales.
Durante la Semana de Concientización sobre la Resistencia Antimicrobiana, se advierte sobre el avance de este fenómeno, que compromete la eficacia de los tratamientos médicos y veterinarios y pone en riesgo la seguridad alimentaria global.
La resistencia a los antimicrobianos (RAM) se produce cuando microorganismos como bacterias, hongos, virus y parásitos desarrollan mecanismos para sobrevivir a la acción de antimicrobianos como antibióticos, antifúngicos, antivíricos, antipalúdicos o antihelmínticos.
Según la Organización Panamericana de la Salud (OPS), “los microorganismos resistentes a la mayoría de los antimicrobianos se conocen como ultrarresistentes. Como resultado, los medicamentos se vuelven ineficaces y las infecciones persisten en el organismo, lo que incrementa el riesgo de propagación a otras personas».
La Organización Mundial de la Salud (OMS) alertó que la resistencia a los antimicrobianos (RAM) provoca más de un millón de muertes al año, cifra que podría incrementarse si no se toman medidas para evitar esta amenaza. Según el organismo, la RAM tiene potencial para revertir avances de décadas y comprometer la salud de personas, animales, plantas y ecosistemas.

Yvan Hutin, director de resistencia antimicrobiana de la OMS, declaró: “Todos los países se enfrentan a la resistencia antimicrobiana. Los patógenos resistentes a los medicamentos están aumentando en todas partes, y cuanto menor sea el acceso de las personas a la prevención, el diagnóstico y el tratamiento adecuado, mayor será la probabilidad de que sufran infecciones resistentes a los medicamentos”.
Las estrategias de prevención
La OMS hizo un llamado a la acción conjunta de autoridades políticas, personal sanitario, veterinarios, agricultores, especialistas en medio ambiente y tratamiento de aguas residuales, investigadores, sociedad civil y comunidades. Al respecto, subrayaron: “Ya sea un administrador hospitalario que crea un equipo de gestión de antimicrobianos o un agricultor que adopta prácticas sostenibles de gestión de residuos, cada acción cuenta”.
La organización sostuvo que “juntos podemos mantener la eficacia de los antimicrobianos y construir un mundo más sano y sostenible para las generaciones venideras”.

La OPS subraya que la RAM representa una amenaza creciente para la salud pública mundial, con consecuencias que trascienden el ámbito sanitario y afectan la producción agropecuaria, el comercio y el ambiente. En ese sentido, el enfoque de Una Salud propone una estrategia multidisciplinaria que involucra a profesionales de la salud humana, veterinaria y ambiental, asignando responsabilidades específicas a cada sector.
En este contexto, los veterinarios desempeñan un papel esencial al implementar estrategias de promoción y prevención en el ámbito agropecuario y al facilitar la colaboración entre los distintos componentes del enfoque Una Salud.
La Organización Mundial de Sanidad Animal destaca que los antimicrobianos, considerados uno de los mayores logros de la humanidad, han permitido mejorar la calidad y la esperanza de vida de personas y animales. Antes de la era moderna, infecciones derivadas de heridas menores podían desencadenar septicemias y causar la muerte. Sin embargo, la aparición de microbios resistentes ha dado lugar a las denominadas “superbacterias”, que desafían la capacidad de médicos, veterinarios y otros profesionales para tratar enfermedades infecciosas, al reducirse las opciones terapéuticas disponibles.

La propagación de cepas bacterianas resistentes en animales terrestres y acuáticos tiene un impacto directo en la subsistencia de millones de personas. Según la Organización Mundial de Sanidad Animal, 1300 millones de personas en el mundo dependen del ganado y más de 20 millones de la acuicultura. El aumento del sufrimiento y las pérdidas animales afectan la economía de los hogares y compromete la seguridad alimentaria global.
La RAM, al revertir décadas de avances médicos y veterinarios, se ha convertido en uno de los principales desafíos sanitarios de la actualidad y es responsable de un número creciente de muertes a nivel mundial.
A pesar de la magnitud del problema, existen soluciones para frenar la emergencia de microbios resistentes. La Organización Mundial de Sanidad Animal sostiene que ganaderos, productores de animales acuáticos, personal sanitario y ciudadanos pueden adoptar medidas para preservar la eficacia de los antimicrobianos.
Entre estas acciones se encuentran la implementación de buenas prácticas de manejo animal, la prevención de enfermedades y el uso responsable de medicamentos. La organización enfatiza que los animales son más vulnerables a las enfermedades cuando se encuentran en ambientes estresantes o con condiciones de higiene deficientes, por lo que la prevención resulta fundamental.

En América Latina, el uso excesivo e inadecuado de antibióticos en animales de producción ha favorecido la aparición de bacterias resistentes, que dificultan el tratamiento de infecciones y ponen en peligro la eficacia de los medicamentos utilizados también en humanos.
Durante la Semana de Concientización sobre la Resistencia Antimicrobiana, expertos y organismos internacionales han reiterado que se trata de un problema global con repercusiones locales, que exige una acción inmediata y coordinada.
El médico veterinario Joaquín Basombrío, especialista en resistencia antimicrobiana de Biogénesis Bagó, explicó: “La resistencia antimicrobiana no distingue fronteras ni especies. Afecta a personas, animales y al ambiente, por eso solo puede abordarse desde una visión integral, bajo el concepto de Una Salud”.
Basombrío también subrayó la importancia de la prevención: “La mejor manera de afrontar una enfermedad es evitar que se produzca. La prevención es el primer paso para proteger la salud animal y, al mismo tiempo, cuidar la salud humana y ambiental”.
La OPS y la Organización Mundial de Sanidad Animal coinciden en que fortalecer los diagnósticos tempranos y los planes sanitarios estratégicos permite evitar enfermedades y reducir el uso de antimicrobianos. Además, la adopción de normas alineadas con los estándares internacionales, la trazabilidad en el uso de medicamentos y la capacitación continua de los trabajadores del sector agropecuario son pasos esenciales para lograr un cambio efectivo.
El compromiso de los veterinarios es clave en este proceso, ya que su labor integra la aplicación de estrategias de promoción y prevención en el ámbito agropecuario y facilita la interlocución entre los sectores animal, humano y ambiental. La OPS invita a todo el gremio veterinario a involucrarse activamente, ejecutando y promoviendo buenas prácticas veterinarias.
La Organización Mundial de Sanidad Animal resalta que, aunque frenar la resistencia a los antimicrobianos puede parecer una tarea desalentadora, ya existen ejemplos alentadores de ganaderos y profesionales de la sanidad animal que han modificado sus prácticas para enfrentar con éxito esta amenaza. La organización concluye que estos esfuerzos protegen a toda la sociedad y que aún queda mucho por hacer para preservar la eficacia de los antimicrobianos para las futuras generaciones de animales y humanos.